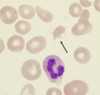

IM Shelf Exam Flashcards
Diagnosing MI in patient with acute chest pain
ECG: 2mm ST elevation immediately, T-wave inversions hours later, Q-waves or new LBBB (wide, flat QRS)
ST elevations seen in occlusion of LAD leading to anterior infarct?
V1-V4
ST elevations seen in occlusion of circumflex leading to lateral infarct?
I, aVL, V4-V6
ST elevations seen in occlusion of RCA leading to inferior infarct?
II, III and aVF
ST elevations seen in occlusion of RCA leading to RV infarct?
V4 on right-sided ECG
Window for delivery of thrombolytics for MI?
Within 6 hours of arrival
Contraindications for thrombolytics?
Current bleed, history of hemorrhagic stroke, recent ischemic stroke and recent closed head trauma
A patient presents to the ED with chest pain, hypotension, tachycardia and JVD with clear lungs. How do you treat this patient?
They have a RV infarct and need fluid resuscitation. Don’t give NO because their RV cannot pump efficiently and decreasing preload will worsen the RV’s ability to pump blood through the pulmonary circulation.
Next step if ECG is normal in a patient with chest pain (r/o NSTEMI)?
Serum troponin q8 hours x 3.
Most sensitive cardiac biomarker for repeat infarct in the hospital?
Myoglobin peaks first within 2 hours and drops by 24 hours. This is much faster compared to CK-MB which rises over 4-8 hours, peaks at 24 hours and drops by 72 hours and Troponin-I which rises over 3-5 hours, peaks by 24-48 hours and drops by 7-10 days.
Treatment for patient with NSTEMI on admission? What do you send them home on?
ON ADMISSION: Morphine, oxygen, nitrates, ASA/clopidogrel, beta-blocker and cath within 48 hours to determine need for stenting or CABG. SEND HOME: beta-blocker, ASA (+ clopidogrel for 9-12 months if stent in place), statin, nitrates prn and ACE-I if CHF or LV dysfunction.
When is CABG indicated over PCI?
Left main disease or three-vessel disease (2 vessels in DM)
Work-up for unstable angina?
Exercise ECG
Meds to stop before undergoing exercise ECG?
Beta-blockers and CCB
When can’t you do an ECG to assess a patient with unstable angina? What do you do instead?
LBBB, baseline ST elevation or currently taking digoxin, must do exercise echo instead.
Work-up of unstable angina if patient cannot exercise?
Chemical stress test with dobutamine or adenosine.
Drugs to avoid prior to nuclear myocardial perfusion scan?
Caffeine or theophylline
When is a stress test positive and what do you do next?
Chest pain is reproduced, ST depressions produced or hypotension in response to exercise. This merits a cath.
Most common cause of death in post-MI period?
V-fib
New systolic murmur 5-7 days after MI?
Mitral regurgitation from papillary muscle rupture.
Acute severe hypotension 5-7 days after MI?
Ventricular free wall rupture
Step up in O2 concentration in RV compared to RA after MI?
Septal wall rupture.
Persistent ST elevations 1 month after MI with a systolic MR murmur?
Ventricular wall aneurism
Cannon A-waves after MI?
AV dissociation due to third degree heart block (AV valve remains closed when atria contract)